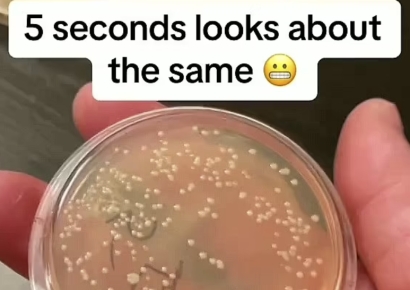
"5초 법칙 믿었는데"…바닥에 떨어진 음식, 1초 만에 세균 '득실'

"와! 한국 진짜 망했군요"…외신도 경악한 '7세 고시' 결국
유명 학원에 들어가기 위해 치르는 시험 이른바 '7세 고시'가 성행할 정도로 한국의 영유아 사교육 시장이 과열 양상을 보이는 가운데 7세 고시를 심각한 '아동 학대'로 규정해 달라는 진정이 국가인권위원회(인권위)에 접수됐다. 16일 국민 1000명으로 구성된 '아동 학대 7세 고시 국민 고발단'은 서울 종로구 인권위 앞에서 '아동 학대 7세 고시 폐지' 기자회견을 열고 교육 당국의 강력한 제재와 영유아 사교육에 대한 전면적인

"집에 간 尹 부부에 꽃다발 준 주민, 안보실 1차장 모친이었다"
윤석열 전 대통령이 서울 서초구 서초동 아크로비스타 자택으로 돌아간 날 그에게 꽃다발을 전달한 주민은 김태효 국가안보실 1차장의 모친이었다는 주장이 나왔다. 17일 JTBC는 "지난 11일 윤 전 대통령 부부가 서울 서초구 아크로비스타 사저로 들어설 때 꽃다발을 건넨 여성은 김 차장의 모친 배 모 씨로 확인됐다"고 보도했다. 김 차장은 윤석열 정부의 외교 실세로 꼽힌다. 당시 윤 전 대통령 부부가 자택에 도착하자 입주민

100g 골드바 삼킨 中 소년…화장실서 내보내려다 결국
중국의 한 소년이 실수로 100g짜리 골드바를 삼키는 사고가 일어났다. 12일(현지시간) 중국 온라인 매체 바스틸레포스트(bastillepost)는 장쑤성 쑤저우시에 사는 11살 소년이 집에서 놀던 중 실수로 100g짜리 금괴를 삼켜 병원에 실려 갔다고 보도했다. 당시 소년은 골드바를 삼킨 후 시간이 갈수록 복통과 복부 팽만감이 심해졌고, 이를 알게 된 부모는 소년을 인근 대학 병원 소아병원 응급실로 데려갔다.엑스레이 촬영 결과 소

한국 최초 '1억 유튜버' 나왔다…1일 예상 수익이 무려 6억
18일 한국 최초로 구독자 1억명을 돌파한 유튜브 채널 '김프로KIMPRO'가 화제다. 김프로는 전날 공식적으로 1억 구독자를 달성한 것으로 알려졌다. 김프로는 유튜브 채널 게시글을 통해 "믿기지 않겠지만 김프로 채널이 1억 구독자를 달성했다"며 "함께 달려온 멤버들과 영상을 봐주시고 응원해주신 구독자 여러분 덕분에 이런 꿈같은 순간을 맞이할 수 있었다. 진심으로 감사드린다"고 전했다. 이어 "숫자에는 여러분의 시간, 관
![[단독]현대차 ‘불법파업 손해배상’ 다시 대법원 갔다](https://cwcontent.asiae.co.kr/asiaresize/93/2025041816194925919_1744960789.png)
현대차 ‘불법파업 손해배상’ 다시 대법원 갔다
최종심에서 파기환송된 현대자동차 비정규직지회 불법 파업에 따른 손해배상 소송이 사측의 이의제기로 다시 대법원 판단을 받게 됐다. 대법원은 2023년 불법 파업에도 매출 감소가 없으므로 손해배상을 하지 않아도 된다며 사건을 고등법원으로 돌려보냈는데, 사측은 매출에 분명 부정적인 영향을 미친 만큼 책임을 묻기 위해 재상고한 것이다. 경영계에선 현대차가 요구한 손해배상 규모가 3억원 정도라는 점을 감안할 때 실질적
!["남는 게 있나요?"…김밥 4000원 시대에 등장한 '1900원' 김밥[먹어보니]](https://cwcontent.asiae.co.kr/asiaresize/93/2025041712555023810_1744862150.jpg)
"남는 게 있나요?"…김밥 4000원 시대에 등장한 '1900원' 김밥
서울 3600원, 경기 3521원, 인천 3300원, 부산 3186원, 광주 3460원…. 한국소비자원 가격정보종합포털 '참가격'에 공시된 지난달 김밥 한 줄의 지역별 평균 가격이다. 서울을 기준으로 전달보다 62원 올랐다. 각종 재료비와 인건비 등이 상승해 실제 매장에서는 일반 김밥 한 줄이 4000원을 넘는 사례도 흔하다. 식품과 음료 등 제조사들이 제반 비용이 증가했다는 점을 호소하며 하루가 멀다하고 제품 가격 인상에 나선다. 반대로

"전·현직 신부와 결혼해요"…단체사진 넣고 청첩장 뿌렸다가 中 발칵
중국에서 한 남성이 여성 두 명과 동시에 결혼한다는 내용의 청첩장을 돌렸다가 예식장으로부터 결혼식을 취소 당하고 경찰 조사까지 받게 됐다. 두 여성 중 한 명은 남성의 전처인 것으로 드러났다. 17일(현지시간) 동남조보, 시나 파이낸스 등 현지 매체에 따르면 중국 남부 구이저우 비제시에 거주하는 우모씨가 오는 19일 2명의 여성과 결혼식을 올릴 예정이라며 지인들에게 청첩장을 발송했다. 해당 청첩장에는 정장 차림의

"1만원 때문에 잘리고 억대 퇴직금도 못 받아"…일본판 '2400원 횡령' 터졌다
1000엔(1만원)의 버스요금을 횡령했다가 면직된 일본 버스기사가 면직 처분 취소와 억대 퇴직금을 달라고 소송했지만 패소했다. 국내서 2400원 요금을 횡령했다는 이유로 해고된 버스기사의 사건과 유사한 사례다. 일본 요미우리신문은 17일 "운임 1000엔 착복으로 면직된 전 교토 시영버스 기사에 대해 대법원이 퇴직금 전액 미지급은 '적법'하다는 판결을 내렸다"고 보도했다. 보도에 따르면 버스기사는 1993년부터 교토시의 시영

故 오요안나 어머니 "당 싸움으로 딸 이름 거론되는 것 싫다"
"(유가족은) 이 사건이 정쟁화되는 것을 원치 않는다. 당 싸움으로 인해 딸의 이름이 좋지 않게 거론되는 것이 싫다." 직장 내 괴롭힘을 호소한 뒤 지난해 9월 숨진 고(故) 오요안나 전 MBC 기상캐스터의 어머니 장연미씨가 18일 국회에서 딸의 죽음이 정치적 논쟁의 도구가 되는 것을 원치 않는다며 진상 규명을 촉구했다. 이날 국회 과학기술정보방송통신위원회(과방위) 현안 질의에 장씨는 참고인으로 출석했다. 김장겸 국민의

트럼프, 파월 해임 논의…'관세 비판' 파월에 "내가 원하면 당장 아웃"(종합)
도널드 트럼프 미국 대통령이 취임 직후 지난달까지 제롬 파월 미 연방준비제도(Fed) 의장 해임을 측근들과 논의한 것으로 전해졌다. 그는 관세 정책으로 인한 경제적 충격을 경고한 파월 의장을 향해 불만을 감추지 않으며 "내가 원하면 당장 쫓아낼 수 있다"고 또다시 해임을 언급했다. 스콧 베선트 미 재무부 장관이 전면에 나서 파월 의장 해임에 반대하고 있지만, 트럼프 대통령의 '결심'만 서면 Fed 의장 교체를 강행할 가능

![[속보]트럼프 "EU와 무역 합의, 관세 유예 종료 전 100% 타결"](https://cwstatic.asiae.co.kr/asiae_v3/com/noimg_thumb.jpg)
![[Why&Next]스벅에 밀리고 '메컴빽'에 치이고…설 곳 잃은 이디야](https://cwcontent.asiae.co.kr/asiaresize/93/2023062108251470631_1687303515.jpg)
![국채 8.1조원 추가 발행…12.2조 중 66% 나랏빚으로 충당[2025 추경]](https://cwcontent.asiae.co.kr/asiaresize/93/2024121910485558911_1734572935.jpg)


